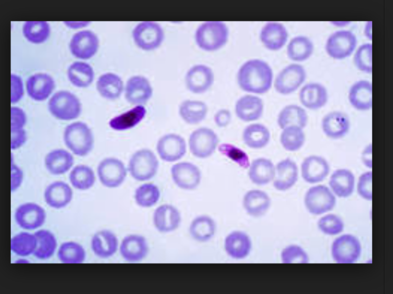

Sign up for FlowVella
Sign up with FacebookAlready have an account? Sign in now
By registering you are agreeing to our
Terms of Service
Loading Flow
Protista: Plasmodium Falciparum
They are eukaryotic cells and are unicellular. This is heterotrophic and they feed on human blood cells. They can reproduce both sexually and asexually. This cells is home to the Eukarya kingdom and the Protista domain. This particular cell can kill young adults but rarely does kill people.